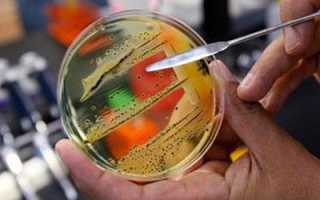
Водянистый понос – причины и особенности лечения

Диарея – это довольно неприятная проблема, которая застает в самый неподходящий момент. Из-за этого недуга человеку приходится корректировать свои планы и отменять встречи. Это состояние очень изматывает как физически, так и морально. Понос водой у взрослого или ребенка может быть по разным причинам и часто проходит без всякого лечения спустя определенное время. Но ждать, когда это состояние пройдет самостоятельно, мало кому хочется, поэтому в ход идут разные медикаменты и народные средства. Чтобы не навредить своему здоровью или здоровью ребенка, важно знать, что можно применять для лечения поноса.
Механизм возникновения водянистого поноса
Водянистый понос у взрослого и ребенка наблюдается в том случае, если в патологическом процессе участвует тонкий кишечник. К этому может привести употребление некачественных продуктов питания или проникновение в организм патогенной микрофлоры. Иной раз объем болезнетворных микроорганизмов в пищеварительном тракте совсем небольшой, но опасность представляют не столько они, сколько продукты их жизнедеятельности. В зимний период причиной водянистой диареи становятся различные вирусы, их еще называют ротовирусами. Заразиться ими очень легко в повседневной жизни.
Врачи отмечают, что водянистый понос может быть вызван различными факторами, включая инфекции, пищевые отравления, аллергии и хронические заболевания. Одной из основных причин является вирусная или бактериальная инфекция, которая приводит к воспалению кишечника. В таких случаях важно не только устранить источник инфекции, но и предотвратить обезвоживание, что может быть опасным для здоровья.
Лечение водянистого поноса часто включает в себя регидратацию с помощью специальных растворов, которые помогают восстановить баланс электролитов. В некоторых случаях могут потребоваться антибиотики, если причиной являются бактериальные инфекции. Врачи также рекомендуют соблюдать диету, исключая жирные и острые продукты, чтобы не усугубить состояние.
Важно помнить, что при длительном течении симптомов или появлении дополнительных признаков, таких как высокая температура или кровь в стуле, необходимо обратиться за медицинской помощью.

Причины водянистой диареи
Понос с водой возникает в ряде случаев, когда нарушается работа пищеварительного тракта. Причины подобного состояния можно выделить так:
- несварение пищи и застойные явления в желудке. Происходит вследствие злоупотребления жирной, копченой пищей, а также при стойком переедании;
- легкая степень пищевой интоксикации;
- аллергическая реакция на разные пищевые продукты, к примеру, индивидуальная непереносимость лактозы;
- лечение определенными лекарственными средствами – слабительными, сердечными или антикоагулянтами;
- стрессовая ситуация или спонтанное волнение, при этом водянистый понос – это следствие большого выброса гормонов в кровь;
- понос путешественников, который возникает из-за смены климата и рациона питания. Чаще всего такая диарея проходит самостоятельно, спустя пару суток, но если понос жидкий, который выглядит, как вода продолжается больше 3 суток, то необходимо искать причину этого состояния в другом;
- болезни, которые вызваны патогенными возбудителями – вирусами, простейшими и бактериями. Чаще всего это сальмонеллез, дизентерия или кишечный грипп;
- воспалительные заболевания органов пищеварения – язвенные болезни или гастрит;
- плохая работа пищеварительных органов из-за недостаточности определенных ферментов;
- заболевание Крона;
- хронические и острые отравления токсическими веществами – ртутью или свинцом.
Во всех этих ситуациях у человека наблюдается понос, который выглядит как вода. Мало просто лечить симптомы, необходимо точно найти причину и только потом проводить комплексное лечение.
В особо тяжелых случаях может понадобиться стационарное лечение, которое будет включать внутривенные вливания, инъекции и физиопроцедуры.
Основные признаки диареи
При легкой степени отравления или же несварении желудка признаки поноса бывают плохо выраженными. Но в таком случае,
кроме поноса, человека беспокоит боль в животе, отрыжка, метеоризм и тошнота, которая изредка заканчивается рвотой
.
Вода вместо кала у взрослого при тяжелых видах отравлений встречается чаще, клиническая картина дополняется обильной рвотой, слабостью и повышенной температурой. Аппетит полностью отсутствует, за счет чего у человека может быть истощение.
Водянистый понос очень быстро приводит к обезвоживанию организма, что представляет большую опасность для здоровья и жизни больного. Основными признаками обезвоживания считается сухость всех слизистых и кожных покровов, а также губ. При этом у человека выраженная жажда, которую невозможно утолить, мочеиспускание скудное, а цвет мочи очень темный. Когда наблюдается обезвоживание, пульс резко возрастает, а артериальное давление, наоборот, падает.
Понос водой у ребенка младшего возраста часто приводит к нарушению работы всех важных органов и систем. В силу малого возраста обезвоживание происходит быстрее, а восполнить потерю жидкости у малышей чаще всего можно лишь посредством внутривенных вливаний.
Водянистый понос — это распространённая проблема, с которой сталкиваются многие люди. Часто его причиной становятся инфекции, вызванные вирусами или бактериями, а также употребление некачественной пищи или воды. Симптомы могут включать частые позывы к дефекации, боли в животе и общее недомогание. Важно помнить, что водянистый понос может привести к обезвоживанию, особенно у детей и пожилых людей, поэтому своевременное лечение крайне важно.
Основные рекомендации включают поддержание водного баланса, употребление электролитных растворов и, в некоторых случаях, применение противодиарейных препаратов. Однако при длительном течении симптомов или наличии крови в стуле следует немедленно обратиться к врачу. Правильное питание и соблюдение гигиенических норм помогут предотвратить повторные эпизоды.

О чем расскажет цвет водянистых испражнений
Довольно быстро установить причину, которая вызвала жидкий стул, можно по цвету испражнений:
- Если в стуле присутствуют вкрапления алой или темной крови, то это свидетельствует о тяжелом течении болезни пищеварительных органов. В таком случае часто прибегают к медикаментозному лечению.
- Понос выраженного черного цвета говорит о кровотечении в верхних отделах пищеварительного тракта. При таком состоянии необходимо срочно обратиться к врачу;
Причиной черного поноса может быть лечение некоторыми специфическими медикаментами, которые придают каловым массам такой цвет – висмута или активированного угля. В этом случае никакое лечение не проводят, цвет нормализуется после окончания приема медикаментов.
- Когда цвет поноса белый, то это говорит о недостатке желчи. Такой цвет испражнений явный симптом гепатита.
- Зеленый цвет стула свидетельствует о размножении в пищеварительном тракте патогенной микрофлоры – простейших, вирусов и бактерий.
- Если жидкий стул имеет желтый оттенок, то это, можно сказать, самый благоприятный прогноз. Такой цвет говорит о типичном несварении желудка и усилении моторики пищеварительных органов. Водянистый понос желтоватого цвета вполне можно лечить в домашних условиях.
- Когда стул, как вода, у ребенка или взрослого, то это, скорее всего, обычное расстройство желудка, а не холера, как считают некоторые люди.
При холере понос водянистый, но он больше похож на концентрированный рисовый отвар. Запах испражнений сладковатый и совершенно не напоминает запах каловых масс.
Во многих случаях выявить точную причину поноса помогает ряд лабораторных анализов и исследований. Но это отнюдь не означает, что обращать внимание на сопровождающие симптомы не стоит. Именно они позволяют поставить предварительный диагноз и назначить лечение еще до прибытия результатов всех анализов.
Общее состояние организма при водянистой диарее
У взрослых пациентов с нормальной массой тела понос водой опасности не представляет, но только если он продолжается не больше суток. У детей, в особенности младшего возраста, продолжительный жидкий стул приводит к обезвоживанию организма. В тяжких случаях это может спровоцировать необратимые последствия и летальный исход.
Как только у малыша появляется понос, его нужно начинать отпаивать дробными порциями, но очень часто. Хорошо подходит лекарственный препарат регидрон, который в составе имеет все необходимые вещества и микроэлементы. Но многие дети с большой неохотой пьют этот неприятный на вкус раствор. Более того, у некоторых малышей регидрон провоцирует приступы рвоты. Если ребенок не может выпить такое лекарство, не стоит его заставлять. Справиться с задачей поможет отвар риса с изюмом или напиток из дольки лимона с медом.
Если наблюдается понос белесой водой, напоминающей рисовый отвар, то можно заподозрить холеру. В этом случае отпаивание ничего не даст, больного нужно срочно госпитализировать. При лечении холеры жидкость вливают внутривенно в больших объемах.
Если состояние человека с водянистым поносом резко ухудшается или появляются новые симптомы, нужно вызывать врача.

Способы лечения поноса
Для лечения водянистого поноса используют разные методики, которые направлены на замедление моторики пищеварительных органов и быстрый вывод токсических веществ из организма.
Различные сорбенты
Быстро излечиться от диареи невозможно без использования сорбирующих препаратов.
Эти медикаменты позволяют мягко и безболезненно удалить из организма токсические вещества и патогенные микроорганизмы
. Они способствуют адсорбции газов, что уменьшает вздутие живота и связанные с этим болезненные ощущения.
Доктора рекомендуют давать сорбенты в качестве препаратов первой помощи при различных отравлениях и кишечных инфекциях. Но нельзя забывать, что перерыв между приемом сорбентов и иных медикаментов должен быть около 1,5 часа, в противном случае лекарства будут неэффективны. Понос водой лечат как при помощи классического активированного угля, так и смектой.
Медикаменты для уменьшения слизи в кишечнике
Помогут излечиться от поноса водой и лекарственные средства, которые снижают выделение слизи в кишечнике. Подобные медикаменты рекомендуется начинать пить с первых суток диареи. На аптечных прилавках можно найти большой ассортимент подобных лекарств, которые мягко снимут воспаление со стенок – это сульфасалазин, индометацин или диклофенак. Такие лекарственные средства можно использовать только для лечения взрослых пациентов, для детей младшего возраста эта лекарственная группа назначается лишь в исключительных случаях.
Лекарственные растения
Ряд лекарственных растений, которые обладают вяжущими характеристиками, поможет в короткий срок избавиться от неприятного состояния. Можно применять аптечную ромашку, лапчатку, кору дуба, кору крушины или черемуху. Лечение проводят при помощи отваров из этой растительности. Пьют их много раз в сутки до нормализации общего состояния.
Ферменты
В том случае, если причиной водянистого поноса стало расстройство пищеварения, помогут ферментные препараты. Они стимулируют выработку желудочного сока и помогают переваривать даже тяжелую пищу. Восстановить функцию всасывания поможет мезим, креон или фестал.
Противодиарейные лекарственные средства
Снизить моторику кишечника помогут противодиарейные средства. При выборе таких медикаментов стоит учитывать первоначальную причину болезни. Так, при водянистом поносе чаще всего прописывают имодиум и лопедиум, но эти лекарства не подходят для лечения поноса, который вызван кишечными болезнетворными бактериями.
Нельзя начинать пить противодиарейные средства при первых позывах в туалет. В таком случае вредные бактерии и вирусы задержатся в организме и будут мешать выздоровлению.
Антибактериальные препараты
Эта группа лекарств часто назначается врачами при лечении водянистого поноса, но только после сдачи всех нужных анализов. Если лечение поноса другими методиками результата не дает, то больному прописывают антибиотик большого спектра действия. При этом тщательно высчитывают дозировку, исходя из веса больного и тяжести состояния.
Антисептики
Эти препараты обладают выраженным антимикробным действием. Они работают лишь в кишечнике и совершенно не всасываются в кровоток. Оказывают губительное действие на кишечную палочку, стрептококки, стафилококки, сальмонеллы и шигеллы. На полезную микрофлору кишечника не оказывают никакого воздействия. Наиболее распространенным лекарством этой группы считается энтерофурил. В то же время интетрикс эффективно борется с бациллой дизентерии и грибками.
Пробиотики
Такие средства помогают в короткий срок справиться с водянистым поносом, ведь это неприятное состояние всегда сопровождается нарушением нормальной микрофлоры кишечника. Для стабилизации состояния прописывают линекс, хилак или энтерол.
Диетическое питание
Вне зависимости от причин, которыми спровоцирована диарея, необходимо строго придерживаться диетического питания. При водянистой диарее нельзя употреблять в пищу такие продукты:
- жареные и жирные продукты;
- копчености;
- бульоны из жирных сортов мяса;
- жирная рыба в любом виде;
- цельное молоко и жирные кисломолочные продукты;
- консервация;
- капуста, огурцы, помидоры;
- бобовые;
- грибные блюда;
- свежую выпечку и кондитерские изделия.
Больному нельзя употреблять газированные напитки, концентрированные соки и любую алкогольную продукцию, включая пиво. Все это плохо влияет на раздраженные стенки желудка.
Всю пищу готовят исключительно на пару или в духовом шкафу, с минимальным добавлением специй и соли. Супы варят на втором бульоне из нежирного мяса. В рационе должны быть крупы и злаки, которые симулируют работу пищеварительного тракта.
Когда беспокоит водянистый понос, необходимо вспомнить, не было ли в рационе перед этим жирной пищи. Если такое состояние нельзя связать с перееданием или несбалансированным питанием, то нужно обратиться к врачу для сдачи необходимых анализов и назначения лечения.
Вопрос-ответ
Что делать, когда понос как вода?
Первым делом начните пить больше жидкости, чтобы предупредить обезвоживание, поскольку при обильном выделении воды при поносе организм может терять 1-3 литров жидкости в сутки5. Затем вызовите врача на дом или запишитесь к нему на прием, если ваше состояние позволяет.
Почему стул стал как вода?
Скорость всасывания жидкости зависит от скорости движения каловых масс. Если они продвигаются слишком быстро (при интенсивных сокращениях стенки кишки), вода не успевает всосаться, и стул становится жидким.
Сколько длится водяной понос?
Диарея при кишечной инфекции может продолжаться 4-7 дней. Для состояния типичен частый стул жидкой консистенции, более 3-4 раз в день (иногда до 15). При этом инкубационный период может занимать до пяти суток, и только после этого начинается понос.
Советы
СОВЕТ №1
Обратите внимание на свое питание. Водянистый понос может быть вызван потреблением жирной, острой или некачественной пищи. Постарайтесь избегать таких продуктов и сосредоточьтесь на легкой, легко усваиваемой пище, такой как рис, бананы и тосты.
СОВЕТ №2
Следите за гидратацией. При водянистом поносе организм теряет много жидкости и электролитов. Убедитесь, что вы пьете достаточное количество воды, а также можете использовать специальные растворы для регидратации, чтобы восстановить баланс.
СОВЕТ №3
Не игнорируйте симптомы. Если водянистый понос продолжается более двух дней или сопровождается высокой температурой, сильной болью в животе или кровью в стуле, обязательно обратитесь к врачу для диагностики и лечения.
СОВЕТ №4
Изучите возможные причины. Водянистый понос может быть вызван инфекциями, аллергиями или стрессом. Попробуйте определить, что могло спровоцировать расстройство, и избегайте этих факторов в будущем.